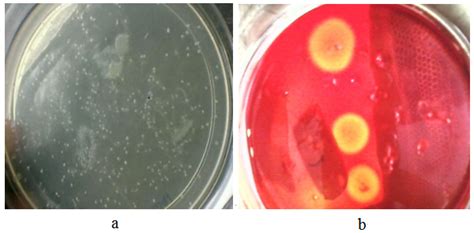

Isolate Cellulose-Degrading Bacteria From Soil Easily
Isolate Cellulose-Degrading Bacteria from Soil Easily
Hey guys, ever wondered about the unsung heroes in our soil? We’re talking about cellulose-degrading bacteria , tiny powerhouses that play a HUGE role in breaking down plant matter. If you’re into microbiology , environmental science , or just love digging into the nitty-gritty of nature, then isolating these critters from soil is a fascinating adventure. It’s not just a cool lab experiment; understanding these bacteria can lead to awesome applications in biofuel production, waste management, and even improving soil health. So, grab your lab coats (or just your curiosity!) because we’re about to dive deep into how you can successfully isolate cellulose-degrading bacteria from good ol’ soil samples . This process involves some classic microbiological techniques , and while it might seem a bit daunting at first, trust me, it’s super rewarding when you finally spot those little guys doing their thing. We’ll cover everything from collecting your soil samples to the crucial steps of culturing and identifying these specialized microbes. Get ready to unlock some serious microbial magic!
Table of Contents
Why Bother Isolating Cellulose-Degrading Bacteria?
Alright, let’s chat about why we’d even want to go through the trouble of isolating cellulose-degrading bacteria from soil . It’s not just for kicks, guys! These bacteria are the rockstars of decomposition. Cellulose is the most abundant organic polymer on Earth, found in plant cell walls. Think of every leaf, twig, and blade of grass – that’s loaded with cellulose. Without bacteria and other microbes to break it down, our planet would be buried under a mountain of plant debris! So, the primary reason is to understand and harness the power of decomposition . But it goes way beyond that. Biofuels are a massive area where these bacteria shine. They can break down cellulose into sugars, which can then be fermented into ethanol or other biofuels. This is a much more sustainable alternative to fossil fuels, and isolating efficient cellulose degraders is key to making this technology viable on a larger scale. Imagine a future powered by plant waste – pretty cool, right? Then there’s waste management . Landfills are packed with organic waste. By introducing or encouraging cellulose-degrading bacteria, we can speed up decomposition, reduce landfill volume, and potentially capture methane, a potent greenhouse gas, for energy. This could revolutionize how we deal with trash! Agriculture is another big one. Healthy soil is teeming with microbial life. Cellulose-degrading bacteria contribute to the nutrient cycle by releasing nutrients locked up in plant residues, making them available for new plant growth. They can also help improve soil structure. So, isolating and studying these bacteria helps us develop better soil amendments and farming practices. Finally, there’s the sheer scientific discovery . Who knows what novel enzymes or metabolic pathways these bacteria possess? Researching them can lead to breakthroughs in biotechnology , creating new enzymes for industrial processes, from food production to textiles. So, yeah, isolating these guys is a pretty big deal for the planet and for future innovation.
Getting Your Hands Dirty: Soil Sampling Strategies
Now, let’s get down to business – collecting the actual soil samples you’ll need to isolate your cellulose-degrading bacteria . This step is crucial , guys, because the diversity and abundance of these microbes can vary wildly depending on where you get your soil. Think of it like fishing; you need to cast your line in the right spot to catch the fish you want! For cellulose degraders, you’ll want to target environments rich in plant material where decomposition is actively happening. Areas like forest floors , especially under leaf litter, compost piles , rotting wood , or even the rhizosphere (the soil zone directly surrounding plant roots) are prime real estate. Avoid heavily disturbed or sterile environments, as they likely won’t harbor a robust population of these specialized bacteria. When collecting, use clean tools – a sterile trowel or spatula is ideal. Collect samples from different depths within your chosen site. For instance, grab some from the surface layer (where fresh plant litter is) and some from a few inches down (where decomposition might be more advanced). This increases your chances of finding different types of cellulose degraders. It’s also a good idea to collect samples from multiple locations within your target area. Don’t just grab one scoop; take several, and maybe even combine them or keep them separate depending on your experimental design. Store your samples properly. If you can’t process them immediately, keep them cool, like in a cooler with ice packs, or refrigerate them. Avoid letting them dry out or overheat, as this can kill off your precious microbes. Seal your samples in sterile bags or containers to prevent contamination. Remember, the goal here is to get a representative sample of the microbial community from an environment likely rich in cellulose and the bacteria that love to eat it. A little care and attention during sampling can make a world of difference in your isolation success. So, be thorough, be clean, and think like a microbe looking for its next meal – where would you hang out?
The Magic Medium: Preparing Your Culture Media
Alright, you’ve got your soil samples, and now it’s time to create the perfect feast for our target cellulose-degrading bacteria . This means preparing a special culture medium . You can’t just slap your soil onto any old agar plate; these guys are picky eaters! The key is to provide cellulose as the sole carbon source. This way, only bacteria that can actually break down and utilize cellulose will be able to grow. A common and effective medium for this is called Carboxymethyl Cellulose (CMC) agar . Here’s the lowdown on how you might prepare it, though always follow specific lab protocols you have. You’ll typically need a base medium like Nutrient Agar or Peptone Water Agar , but crucially, you’ll add CMC as the primary carbon source. A typical recipe might involve dissolving CMC powder in distilled water and then incorporating it into your sterilized agar base. You’ll also need a nitrogen source (like ammonium sulfate or yeast extract, but in controlled amounts so cellulose remains limiting) and essential salts (like potassium phosphate and magnesium sulfate) for bacterial growth. Sterilization is non-negotiable, guys! Autoclaving is the gold standard to ensure no other pesky microbes from your equipment or ingredients contaminate your plates. Once sterilized and slightly cooled (but still liquid), you’ll pour the agar into sterile Petri dishes. Let them solidify completely before you start inoculating. Some protocols might use liquid media (like CMC broth) instead of agar, especially for enrichment cultures before plating. This allows bacteria to multiply in a liquid environment. For isolation, solid agar plates are usually preferred because they allow you to get distinct colonies, each originating from a single bacterial cell. Getting the medium just right is like setting the stage for a microbial performance. You want conditions that favor your cellulose degraders and discourage everyone else. So, precise measurements and meticulous sterilization are your best friends here. The CMC agar is your secret weapon to specifically coaxing out those cellulose-eating microbes from the complex soil soup.
Culturing Your Critters: Inoculation and Incubation
With your sterile CMC agar plates ready, it’s time for the exciting part: inoculation and incubation ! This is where you introduce your soil sample to its new home and give it the perfect conditions to grow. First, inoculation. You want to get a small, representative amount of your soil onto the agar surface. The most common method is serial dilution and plating . Take a small weight of your soil (say, 1 gram) and mix it thoroughly with a known volume of sterile saline or water (e.g., 9 ml). This is your 10⁻¹ dilution. Mix well. Then, take 1 ml of this mixture and add it to another 9 ml of sterile diluent to get a 10⁻² dilution, and so on. You’ll typically go through several dilutions (10⁻³, 10⁻⁴, 10⁻⁵, 10⁻⁶, etc.) to reduce the bacterial load and get countable colonies. Once you have your dilutions, spread a small volume (like 0.1 ml) from a few key dilutions (e.g., 10⁻⁴, 10⁻⁵, 10⁻⁶) evenly across the surface of your CMC agar plates using a sterile spreader (often a bent glass rod or a disposable plastic spreader that’s been sterilized). Flame sterilization of the spreader between each plate is crucial if you’re using a glass rod. Alternatively, you can use the pour plate method , where you mix a small amount of your diluted sample with molten agar before pouring it into the plate, but spreading is more common for isolating specific types. After inoculation, the plates need to incubate . This is where the magic happens! The optimal temperature will depend on the types of bacteria you’re trying to isolate, but a common range for soil bacteria is 28-30°C (mesophilic) . Incubate the plates in an incubator for a suitable period, usually 24 to 72 hours , or sometimes even longer, as cellulose degradation can be a slow process. The plates should be incubated upside down (agar side up) to prevent condensation from dripping onto the colonies and spreading them. What you’re looking for are colonies that appear distinct and are growing well on the CMC medium. These are your potential cellulose degraders! Keep an eye on the plates; you might see different colony morphologies, which could indicate different species.
Spotting Your Stars: Detecting Cellulose Degradation
So, you’ve got colonies growing on your CMC agar plates. Awesome! But how do you know for sure which ones are actually degrading cellulose ? Just growing on the plate doesn’t prove it; they could be using trace contaminants or other carbon sources. We need a specific test to visualize cellulose breakdown. The most common and effective method is using a staining technique , typically with Congo Red . Here’s how it works, guys: After your initial incubation period (around 48-72 hours, or until you see good colony growth), you’ll flood the surface of the agar plate with a 0.1% Congo Red solution . Let it sit for a few minutes – usually about 5-15 minutes. Congo Red is a dye that binds to the long polysaccharide chains of undegraded cellulose. Bacteria that can degrade cellulose will have broken down the CMC in the agar around their colonies. This means there’s less intact cellulose in those areas for the Congo Red to bind to. So, what you’ll see are clear zones (halos) around the colonies that have successfully degraded the cellulose. The colonies themselves might appear pink or red, but the surrounding agar will be stained red where cellulose is still present. The colonies surrounded by a distinct, clear halo are your positive isolates – the ones that are truly cellulose degraders! If a colony has no clear halo around it, it means it likely can’t efficiently break down CMC. After observing the clear zones, you’ll need to pick these colonies. Using a sterile inoculation loop or pipette tip, carefully transfer a small piece of the colony (and the surrounding clear zone, if possible) from the original plate to a fresh plate of CMC agar . This is called re-streaking or sub-culturing . This step is vital to purify your isolate, ensuring you’re not carrying over other non-degrading bacteria from the original mixed colony. Incubate these new plates again. You’re looking for the same clear zone formation around the re-streaked colonies. This purification step is key to obtaining a pure culture of a specific cellulose-degrading bacterium.
Purification and Further Characterization
Once you’ve identified potential cellulose-degrading bacteria using the Congo Red assay and have re-streaked them onto fresh plates to get isolated colonies, the job isn’t quite done yet, guys! The next critical phase is purification and further characterization . Even after re-streaking, you might still have a mixed culture, so repeating the purification process is often necessary. This typically involves picking a single, well-isolated colony from your re-streaked plate and streaking it onto another fresh CMC agar plate. You might do this two or three times to be absolutely sure you have a pure culture – meaning only one type of bacterium is present. Once you’re confident you have a pure culture, you can start to characterize your isolates. This is where you delve deeper into understanding what you’ve found. Microscopic examination is a fundamental step. Use a microscope to observe the cell shape (cocci, bacilli, spirilla), arrangement (clusters, chains), and Gram staining properties (Gram-positive or Gram-negative). This gives you basic taxonomic clues. Biochemical tests are also super important. These are tests that identify specific enzymes or metabolic capabilities of the bacteria. For cellulose degraders, you might test for their ability to break down other compounds, their growth requirements (e.g., oxygen needs – aerobic, anaerobic, facultative), and their production of other useful enzymes. Molecular identification methods, like 16S rRNA gene sequencing, are the gold standard for accurately identifying bacteria to the species level. While more advanced, this technique provides definitive identification. You can also perform quantitative assays to measure the rate of cellulose degradation or the types of sugars produced. So, purification ensures you’re working with a single organism, and characterization helps you understand its unique properties, paving the way for potential applications. It’s about moving from a vague